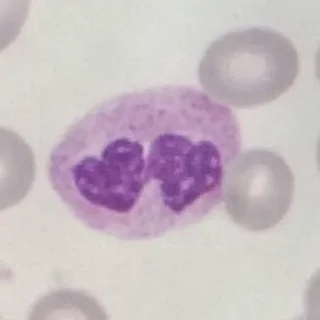
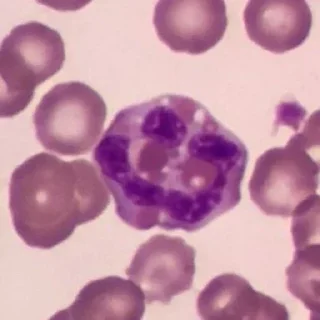

Также смотрят эти стикер паки:

Night Wolf @stickersb2b
NightWolf_Stickers

Uramichi Oniisan • @Y2Lab
UramichiOniisan

Светлый Ян (@TgSticker)
svetliyan_vk

Південний парк
SouthParrkk

Налоги, законы @oooavirta
Nalogiizakon_marat

Варя пиздатая :: @fStikBot
varjore_by_fStikBot

Чай з малинавым варэннем
belteanews

Beast Boy ➩ @Earth928B
BeastBoyEarth928B

@ShemiSoseda
USoseda

chpic.su • @Premium_Emojis_Telegram | Стервятник
VultureOK

I love Smeshariki
IloveSmeshariki
Valentine's Day @Sticker_Awwww
ValentineSticker2025

cartiii / by @xarteffer
ukurishkarti

Минт от @stickers_vk
mint_iz_vk

Безумный азарт @anime_stickerr
Sysyydsw